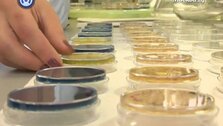

20 июня 2012, 11:23
"Формула качества": газировка
Россияне особенно полюбили газировку только в советские послевоенные годы. Были нелегкие времена, и газировку в качестве поощрения покупали детям. Сегодня главное в газировке не цена, а состав. И прежде чем дать ребенку шипучий напиток, внимательно прочтите этикетку.








Собянин объявил об открытии обновленного корпуса ГКБ № 1 им Н. И. Пирогова